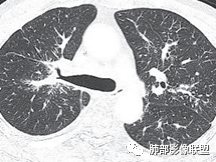
【病例】肺部这样的片状影，你是否能一锤定音？-31
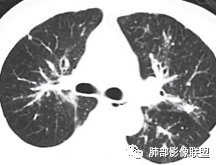
【病例】肺部这样的片状影，你是否能一锤定音？-33

【病例】肺部这样的片状影,你是否能一锤定音?
发布时间:2022-10-22
发布时间:2022-10-22









群内讨论
秦化君:左肺上叶不均匀实变影,边缘部分清晰,近端支气管通畅,纵隔及左肺门淋巴结肿大,左上肺局部淋巴管炎。左侧胸腔积液,心包积液。考虑恶性病变,淋巴瘤?腺癌?
飞鹰行动:老年男性,左肺病灶,边缘模糊,右肺下叶可见小片状阴影,纵膈淋巴结稍增大,心包少量积液,考虑感染性病变,结核?肺克?
宇宙:老年男性,糖尿病史,左肺上叶及舌叶实变伴局部小叶间隔增厚,沿支气管血管束分布,密度不均,肺门浓密,支气管未见明显阻塞,考虑腺癌,鉴别结核。
我只是邓较瘦:考虑多原发腺癌伴癌淋,鉴别淋巴瘤。
良孑:左上叶不张,左上叶支气管渐进行狭窄,不张内支气管走行僵直呈串珠状,纵隔内淋巴结肿大,左侧斜裂胸膜上多发结节,纵隔旁小叶间隔增厚,高龄,炎性标志物正常,首先考虑恶性占位腺癌,其次鉴别一下支气管TB。
放射线:左肺上叶实变,沿着支气管走行分布,支气管部分阻塞部分扩张,周围小叶间隔及中轴间质结节状增厚,纵隔淋巴结肿大,心包积液,考虑腺癌伴癌淋,心包转移,右肺磨玻璃结节并胸膜牵拉凹陷,考虑IAC。
谢加平:左肺门旁团块影,上叶支气管开口严重狭窄,中轴及小叶间隔增厚(示淋巴回流受阻),左肺叶阻塞性肺炎,纵隔淋巴结肿大,支持恶性,肺腺Ca,另见右肺上叶后段胸膜下亚实性结节,叶间胸膜牵拉明显,考虑lAC。甲状腺右叶结节性甲状腺肿?支气管镜检查!
衡妈:左肺门见大片状不规则软组织密度,左肺上叶近端支气管管壁僵直,分支堵塞,病灶周围结构紊乱,小叶间隔增厚且伴结节感,考虑淋巴管炎;纵隔淋巴结肿大。炎性指标正常,考虑肿瘤性病变,腺癌伴周围癌性淋巴管炎可能,鉴别结核。
流心明智:男,69,咳嗽、咳痰1月。胸部CT:甲状腺右叶结节;左上肺大片状不规则软组织密度影,病灶周围结构紊乱,中轴间质不均匀增厚,小叶间隔结节样增厚,支气管充气征,枯枝?;右上叶后段胸膜下mGGN,周围磨玻璃界清,叶裂牵拉凹陷;纵隔多发淋巴结肿大。考虑肿瘤,腺癌伴癌淋?转移瘤?鉴别结核。
离殇:老年男性,双肺多发病变,以左肺较著,右肺上叶后端可见混合磨玻璃病变,边缘清晰,病灶内支气管扩张,考虑腺癌?慢性炎症?左肺片状/斑片状密度增高影,左肺多发小叶间隔增厚,未见明显结节影,支气管未见明显截断征象,肺门/纵隔淋巴结增大,心包及左侧胸腔少量积液,考虑恶性,腺癌?结核?;甲状腺右侧叶类圆形密度减低影,边缘尚清,考虑结节性甲状腺中,左侧肩胛骨下部肌肉内脂肪密度影,考虑脂肪瘤。
AAA张春雨:肺部联盟病例:纵隔向左移位,提示慢性疾病,心包积液,左肺上叶内侧段不张,纵隔淋巴结肿大但不是肿瘤转移的填塞式的大淋巴结,考虑支气管内膜结核,结核性心包炎。
大咖分析


南边:老年人,糖尿病,有点低蛋白。
 |
 |
 |
 |
南边:问个问题:病灶累及整个上叶,如果考虑肺癌:中央型?周围型?中央型:支气管堵塞:远端不张,符合吗,不符合,周围型:外周朝内带推移:符合吗?如果恶性:那就是考虑转移?
 |
 |
南边:壁有增厚,不是很明显。
 |
 |
南边:这些是中轴间质增厚?树芽征?
Coke with ice:潘老师,这里是小叶间隔吧?串珠样的。
南边:是的。
图不太清楚,符合感染,我看不清支气管壁增厚时壁内软骨的密度,我认为是间质增生为主的病变,不是气道。
 |
 |
 |
 |
南边:尖后段弥漫小叶间隔,中轴间质增厚,部分有结节感,大家考虑啥。
Coke with ice:我觉得是典型的癌淋,较大范围的,比如叶分布,甚至是整个单侧肺,单侧的肺小叶间隔增厚,极大概率是癌淋,另外一个疾病谱就是负压性肺水肿。

Coke with ice:这里有点像原发。隆突下也有大淋巴结。
需要注意的是,肺外来的转移瘤也可以这个表现。

Coke with ice:这里感觉也疙疙瘩瘩的。
晨读结果
病理结果:腺癌

因为组织少,没有做免疫组化。上靶向药了,选的埃克替尼。
回顾分析
一、简要病史:老年男性,咳嗽咳痰1月,少许白痰、易咳出,稍感胸闷,无发热等其他不适。既往糖尿病及右下肢深静脉血栓病史,无吸烟史。二、实验室检查:CRP稍高,白细胞正常,无其他有价值的实验室检查提供。
三、影像表现:左肺上叶多发片状高密度影,散在,边缘模糊,支气管壁稍增厚,中轴间质、小叶间隔增厚、有结节感,左肺上叶前段病灶可见胸膜增厚,部分小支气管不能分辨;右肺上叶后段混合磨玻璃结节,边界清,邻近胸膜凹陷;纵膈淋巴结肿大;心包增厚;左侧少量胸水。此外,扫及右侧胸腔内甲状腺肿;左侧肩胛骨旁肌群内脂肪瘤。
四、综合分析:老年男性,以咳嗽咳痰为主要临床表现,无发热,白细胞正常,影像表现为左肺上叶片影,前段结节影、胸膜增厚、部分小支气管不能分辨。左肺上叶中轴间质增厚、小叶间隔增厚、结节感,肺门纵隔见肿大淋巴结,尽管肺部病病灶边缘特征不典型,但高度疑及癌性淋巴管炎这一“次生灾害”却具有相当重要提示意义,而肺癌中最常伴癌淋的就包括腺癌。右肺上叶后段混合磨玻璃结节,边界清楚,张力明显,具有一定特征性,高度指向浸润性腺癌。这对于左肺病灶具有一定程度“助攻”效应。总体而言,本例左肺病灶的诊断关键点在于判断出癌性淋巴管炎。癌性淋巴管炎的结节在外围间质多见,小叶间隔可呈串珠状、结节状增厚,由于出血及水肿,小叶间隔增厚较明显,或呈不规则增厚。有的肺小叶呈多角状阵列。常合并胸水。
五、鉴别诊断:除了腺癌外,需要鉴别的疾病有:支气管内膜结核、淋巴瘤、其他感染性病变。1、支气管内膜结核主要表现支气管壁不均匀增厚,狭窄与扩张相并存,支气管断端多呈鼠尾状或锥状,无明显软组织肿块,可出现阻塞性肺不张,管壁出现钙化对于诊断支气管内膜结核有较大价值,支气管结核播散到肺内时表现为以小叶为中心的多发小结节影及斑片影, 新旧不等,可见较为硬朗的“树芽征”、“拐枣征”,可伴有肺门及纵膈淋巴结肿大、钙化。2、肺内淋巴瘤的影像表现都具有一些主要的特征性表现。①病灶的分布:因为肺内淋巴瘤主要侵犯对象是肺间质和支气管黏膜下组织,病灶主要位于在沿支气管血管束分布、肺间质及胸膜下,有时病灶可跨叶分布;②病灶的密度:密度均匀,偏柔和,轻中度均匀强化;③支气管充气征伴或不伴支气管扩张:肿瘤细胞沿肺间质及支气管黏膜下组织浸润,支气管管壁未见明显破坏,管腔内未见肿瘤细胞充填,呈现充气支气管征;充气支气管走行自然,无扭曲、僵硬,内壁管腔光滑,支气管管壁见增厚并常有管腔的扩张,含气支气管可呈串珠样不均匀扩张,扩张明显处呈空腔样或皂泡样的囊状含气影;支气管扩张目前有两种意见:一是由于肿瘤组织起源于肺间质,肿瘤沿或跨越脏器解剖结构生长,原有解剖结构残留,周围增生的纤维结缔组织牵拉导致支气管扩张;二肿瘤侵犯支气管粘膜下植物神经丛致平滑肌张力丧失;而这类支气管扩张在肿瘤治疗后有时可消失;④血管造影征:肿瘤组织浸润引起间质增厚、肺泡壁破坏、肺泡腔充填,而周围充盈血管走行自然,未受肿瘤侵犯。⑤病灶的边缘:有膨隆,浅分叶,也有平直、收缩,平直收缩是因为肿瘤组织浸润致肺泡塌陷及周围纤维组织增生,牵拉正常的肺组织向病灶中心形成聚拢状改变,似呈“炎性”改变。⑥间质性改变:多位于病灶周围,可见边缘磨玻璃密度影或晕征及树芽征象,周围组织间质增厚并且有结节感,病理基础为肿瘤细胞浸润细支气管周围间质及肺泡壁。3、其他肺内感染性病变,一般多有发热、咳嗽等肺部感染性症状,实验室检查炎性指标异常,影像表现多样,不同的病原体可有不同影像学表现,可表现为斑片影、磨玻璃影及大片实变影,伴或不伴胸水。需密切结合临床、实验室检查及影像学表现方可做出合理诊断。
06癌淋文献学习
肺癌性淋巴管炎(PLC)是肺内、外肿瘤肺转移的一种特殊类型,以 转移癌细胞在淋巴管内弥漫性生长为特征,占肺内转移瘤的6.8%。癌 细胞可播散至肺淋巴管及血管,最终因呼吸衰竭和肺源性心脏病而导致病死亡。临床症状主要为干咳、憋气、体重减轻及低氧血症。本病预后极差,50%~85%的患者生存期3~6个月,临床诊断较困难,常误诊为其它肺间质性病变。 PLC的主要CT征像当中肺纹理异常改变最常见,肺纹理不规则增多、增粗并多发微小结节状更形象解释癌细胞在淋巴管内生长成结节及周围间质增生,导致淋巴管通道堵塞,远处淋巴液回流受阻,通过其它细小交通回流,从而导致肺纹理增粗增多,是PLC较有特征性CT征象,其它疾病所导致的肺纹理增多增粗一般较规则,可为粗细不均或受牵拉变形却极少出现结节状增粗并呈串珠状排列。小叶间隔不规则增厚并多发小结节也是因为小叶间隔淋巴管癌细胞生长及淋巴管通道受阻扩张所致,虽然小叶间隔结节状增粗,但小叶结构不变形是PLC较为特征的CT表现,肺纤维化、 肺水肿、肺胶原病及结节病等肺间质性病变中较少见小叶间隔结节状增粗,而且它们一般导致肺小叶结构变形。肺小叶内间质增生及(或)核心小结节无明显特异性,其表现与特发性肺纤维化、 尘肺及结缔组织病及其它可导致肺间质性纤维化疾病的小叶内间质增厚相类似。PLC导致的胸膜增厚也有一定特征,一般累及胸膜范围较广,程度轻,密度较淡, 部分呈花边样改变,以叶间胸膜较常见,绝大部分病例叶间胸膜受累呈轻度增厚并沿表面排列多发微小结节,伴随PLC其它征象,未见单独存在。肺内结节及 (或)小斑片状实变影无特异性, 与肺结核、炎症、肺血行转移瘤及类风湿等结缔组织病的肺部表现相似,也可能为合并血行转移及肺部感染。纵膈及肺门淋巴结肿大、胸腔及心包积液均无特异性,曾有文献报道,单侧叶间裂积液对PLC的诊断有相对特异性, 因单侧的叶间裂积液主要是由于胸膜下淋巴管堵塞,淋巴回流受 阻所致,可提示PLC的存在。
综合上述,肺纹理不规则增粗并多发微小结节、肺小叶间隔不规则增厚并多发微小结节、轻度增厚的胸膜并多发微小结节对诊断PLC具有重要意义,三者征像同时存在时,结合肿瘤病史及临床症状, 基本可以明确诊断PLC。
 |
 |
|
 |
|
 |
图1、2为同一病例,左肺下叶背段周围型肺Ca并左肺下叶局限型PLC,肿块与左下肺门间肺纹理不规则增粗,肿块与膈面有串珠样高密度影相连。图3为乳腺癌化疗后多发转移并弥漫型PLC,双肺多肺叶肺纹理不规则增粗增多并多发微小结节,其中右肺上叶后段肺纹理多呈典型的“毛刷征”,双肺上叶胸膜下区可见多发垂直于胸膜的不规则增厚的小叶间隔及微小结节。图4为右肺上叶周围型肺癌并弥漫型PLC,左肺上叶背段肺纹理不规则增粗增多呈典型的“毛刷征”,右侧叶间胸膜轻度增厚及多发微小结节。图5为胰腺癌术后多发转移并弥漫型PLC,双肺广泛肺纹理增多增粗并多发微小结节,双肺胸膜下多发肺小叶间隔增厚并见微小结节;图6(MPR冠状位)为食管癌术后肺弥漫型PLC,左肺广泛肺纹理不规则增多、增粗及多发小结节,边缘模糊。
PLC主要与可导致肺纹理、小叶间隔不规则增粗并多发微小结节的间质性肺疾病鉴别,主要有结节病、肺结缔组织病、尘肺及淋巴瘤肺部浸润等。
结节病是一种原因不明的多系统非干酪性肉芽肿疾病,与 PLC鉴别较困难,一样可见肺门及纵隔淋巴结肿大,支气管血管束和小叶间隔也可呈串珠状结节改变,但其小叶间隔及胸膜不规则增厚及小结节明显较PLC少,且其异常肺纹理分布以双侧肺门周围较为常见,肺小叶结构常扭曲变形,双侧肺门淋巴结呈对称性 肿大且边界较清,密度较高且均一,病史一般较长,症状反复。
肺结缔组织病以结缔组织和血管的广泛炎性损坏和纤维蛋白样物质沉积于结缔组织及血管壁上为特征的自身免疫性疾病,可表现为弥漫性支气管血管束增厚和多发小结节影。常见的病因是系统性红斑狼疮(SLE)、类风湿病等。SLE免疫指标异常(血清y球蛋 白升高,C3、C4降低),在周围血液及骨髓中找到SLE细胞具有关键诊断意义。SLE常导致间质性肺炎及肺间质纤维化,肺部阴影可呈游走性,用激素治疗效果良好, 而PLC无此特征。类风湿(RA)病实验室检查:类风湿性因子阳性, 抗核抗体部分阳性,胸膜下可分布类风湿结节,直径1cm左右、边缘光整、可形成空洞,与皮下类风湿结节相并行,这有助于与PLC鉴别。
尘肺在CT上其表现的小结节常“游离” ,偶或也可沿淋巴管走行分布,小叶间隔增厚可呈串珠状,但不如癌性淋巴管炎广泛,也没有小叶间隔或叶间裂胸膜分布优势,而且癌性淋巴管炎多同时伴有血行转移。尘肺结节密度比较高,分布以双上肺较为密集,结节有融合征像, 部分可形成斑块并见钙化,双侧肺门及纵隔肿大淋巴结常见有钙化,有不同程度的弥漫性肺间质纤维化,影像学改变明显而临床症状相对较轻也是尘肺的特征之一。其职业史和粉尘接触史对鉴别诊断很重要。
淋巴瘤肺内浸润也表现为双侧肺门及纵隔淋巴结肿大,肺纹理不规则增多增粗并多发小结节,这点与PLC表现非常相似,其肺纹理微小结节表现虽然与PLC的一致,但其经常在外周分布一些直径10mm左右的较大结节,而PLC无此征像。Honda等学者认为PLC小叶间隔增厚和胸膜下间质病变 (间质结节和间隔不规则增厚)明显高于淋巴瘤肺内浸润,且淋巴瘤肺内浸润对放疗化疗均较敏感 。
肺纹理、肺小叶间隔及胸膜不规则增厚及多发小结节为PLC较有特征性的CT征像,应用高分辨螺旋CT的多种模式重建细心观察 可清晰显示,薄层靶重建、MPR及 MIP对显示微小结节与肺纹理、小叶间隔及胸膜的关系尤其重要。
参考文献:肺癌性淋巴管炎CT表现的特征性分析 李水连 张海涛 余水全 肖格林